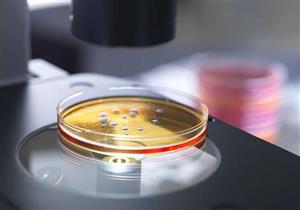
"التراب" لقتل البكتيريا المقاومة للأدوية

إعلان
-
11 نوفمبر, 2020
-
16 ديسمبر, 2018
-
13 فبراير, 2018
-
15 فبراير, 2018
إعلان
إعلان